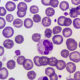
Inductores de crecimiento

La fosforilación oxidativa es un proceso bioquímico esencial en las células eucariotas que se lleva a cabo en las mitocondrias, donde ocurre la producción eficiente de energía en forma de adenosín trifosfato (ATP). Este proceso es parte de la cadena respiratoria, que aprovecha la energía liberada durante la oxidación de sustratos como la glucosa para generar ATP. La eficacia de esta producción se traduce en la generación de aproximadamente 36 a 38 moléculas de ATP por molécula de glucosa, un fenómeno que implica varias etapas y complejas interacciones moleculares.
La glucosa, un carbohidrato fundamental, se descompone a través de la glucólisis en el citoplasma celular, produciendo moléculas intermedias y liberando energía en forma de ATP. A continuación, las moléculas resultantes ingresan a la matriz mitocondrial, donde comienza el ciclo de los ácidos tricarboxílicos (ciclo de Krebs). Este ciclo metabólico es vital para la oxidación completa de los fragmentos de glucosa y la liberación de electrones de alta energía.
Los electrones liberados en el ciclo de Krebs son transportados por una serie de complejos de proteínas en la cadena respiratoria de la membrana mitocondrial interna. Con cada transferencia de electrones a través de esta cadena, se libera energía que es utilizada para bombear protones (iones de hidrógeno) desde la matriz mitocondrial hacia el espacio intermembrana. Esta acumulación de protones crea un gradiente electroquímico, con una mayor concentración de protones en el espacio intermembrana en comparación con la matriz.
La liberación de energía acumulada en el gradiente protónico se canaliza a través de una enzima llamada ATP sintasa, que actúa como una especie de turbina molecular. A medida que los protones fluyen de vuelta a la matriz a través de la ATP sintasa, la energía liberada se utiliza para convertir el adenosín difosfato (ADP) en ATP, la moneda energética de la célula.
La producción de 36 a 38 moléculas de ATP por molécula de glucosa se debe a varios factores, como la eficiencia de los complejos de la cadena respiratoria en transportar electrones y generar gradiente protónico, así como la actividad de la ATP sintasa en la síntesis de ATP. Esta variabilidad en el rendimiento de ATP se debe en parte al funcionamiento específico de los sistemas de transporte de electrones en diferentes tipos celulares y condiciones metabólicas.